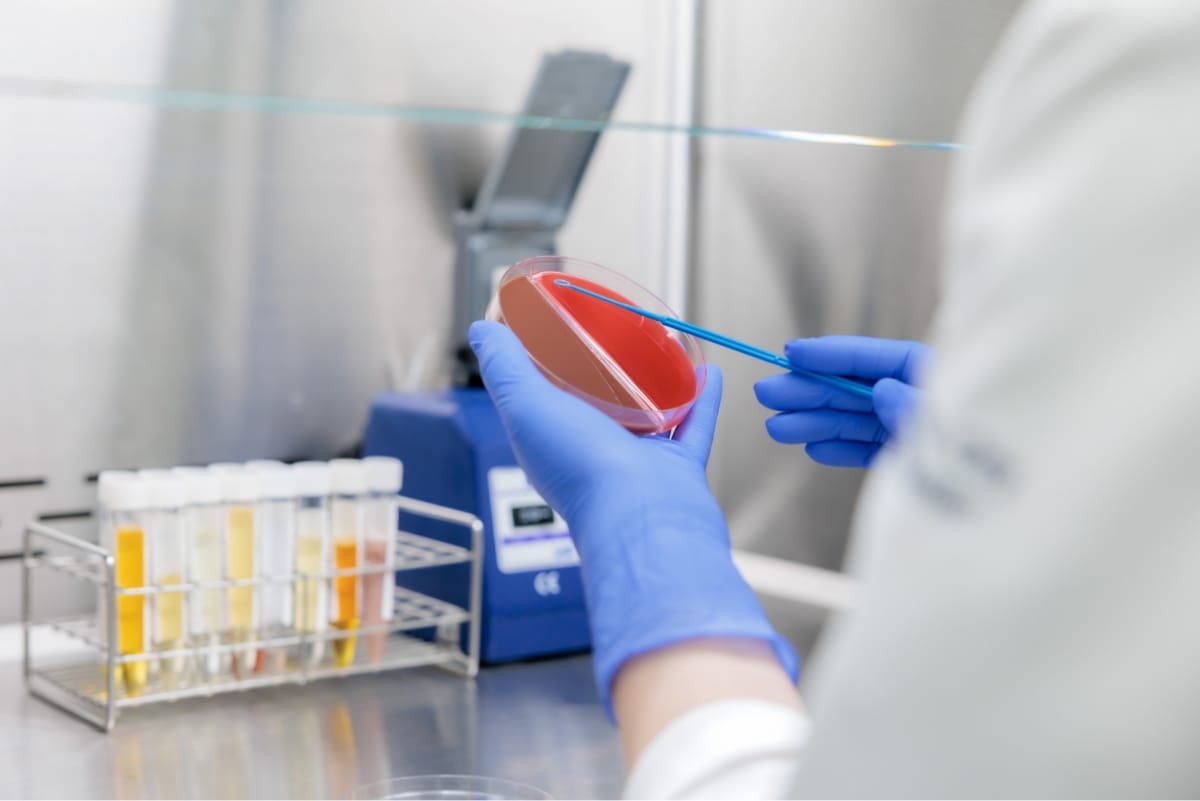

細菌検査室では「感染症の原因となる細菌や真菌を特定し、どの抗菌薬に対して効果があるか」を調べることが主な業務です。このため、さまざまな患者検体(血液・喀痰・尿など)を用いて塗抹検査、培養・同定検査、抗菌薬感受性検査を実施します。
| 臨床検査技師 | 4名 |
|---|
検体をスライドガラスに塗布し、グラム染色後、顕微鏡で観察します。感染症の原因となる細菌の推定や炎症細胞の有無が把握できます。

白血球に貪食されたグラム陽性球菌

白血球に貪食されたグラム陰性桿菌
検体を培地に塗布し、菌の発育に適した温度で培養を実施すると、24~48時間後にコロニー(集落)を形成します。同定検査では、このコロニーを用いて質量分析装置や生化学的性状から菌名を決定します。

感染症の原因と考えられる細菌が分離された場合、どの抗菌薬に対して効果があるか、自動機器を用いて抗菌薬感受性検査を実施します。また、MRSAなどの各種抗菌薬耐性菌も感受性検査で判明します。

結核菌など、抗酸菌による感染症の原因菌を特定します。抗酸菌は発育に数週間を要するため、当検査室では迅速報告が可能な塗抹検査(蛍光染色、チールネルゼン染色)および遺伝子検査(PCR)を実施しています。

インフルエンザや新型コロナ、マイコプラズマなど、流行性の疾患、院内感染の原因となり得る疾患、培養困難な菌では、迅速検査キットを用いることにより夜間・休日でも検査可能とし、迅速に治療や介入が行える体制を構築しています。
院内感染対策チーム(ICT)、抗菌薬適正使用支援チーム(AST)の一員として、細菌検査結果をもとに耐性菌やアウトブレイクの監視、適切な抗菌薬治療、POT法を用いた分子疫学的解析の実施など、他職種と協力して感染制御活動に取り組んでいます。

POT法による分子疫学的解析(MRSA)
稀な菌による感染症や各種症例、検討、集計など、学会発表や論文投稿を積極的に行い、認定臨床微生物検査技師の資格取得に向けての教育にも取り組んでいます。